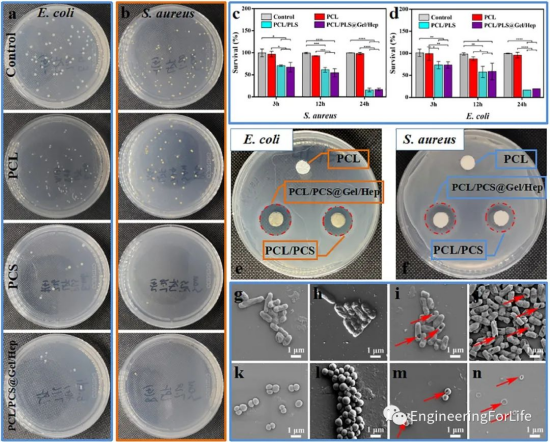

电纺纳米纤维支架能有效模拟细胞外基质,在创伤愈合方面显示出巨大的应用潜力。三维(3D)纳米纤维敷料具有良好的组织相容性、促进伤口愈合和减少炎症能更好地模拟天然细胞外基质(ECM)。在此,糖心vlog
江国华课题组,通过静电纺丝和气体发泡的方法设计了三维聚己内酯/聚赖氨酸改性壳聚糖(PCL/PCS)纳米纤维支架。然后,通过静电吸附将明胶和肝素(Gel/Hep)组装到PCL/PCS纳米纤维表面,并将血管内皮生长因子(VEGFs)同步掺入到Gel/Hep层中,形成多功能三维纳米纤维支架(PCL/PCS@Gel/Hep+VEGF)以促进伤口愈合。相关研究“Design of 3D polycaprolactone/ε-polylysine-modified chitosan fibrous scaffolds with incorporation of bioactive factors for accelerating wound healing”于2022年9月7日发表在杂志《Acta Biomaterialia》上。

图形摘要
电纺丝是一种快速、高效、不间断制备均匀纳米纤维支架的方法。近年来,纳米纤维支架在组织工程(骨、软骨愈合、神经再生、血管再生、皮肤愈合等)、药物输送和癌症治疗等方面的应用取得了很大进展。电纺纳米纤维支架具有超细纤维尺寸和高比表面积的特点,这使其在组织工程再生领域具有良好的发展前景。三维(3D)纳米纤维创面敷料不仅要保持较大的比表面积和良好的透气性,而且要具有优异的吸水性。本文以聚己内酯/聚赖氨酸改性壳聚糖(PCL/PCS)为骨架,模拟细胞外基质,制备电纺三维纳米纤维支架。通过静电吸附将明胶和肝素(Gel/Hep)组装到PCL/PCS纤维表面,并将血管内皮生长因子(VEGFs)同步掺入到Gel/Hep层中,形成了多功能三维纳米纤维支架。如图1所示,这种多功能三维纳米纤维支架具有良好的抗菌能力、血液相容性和生物相容性,可通过抑制伤口部位的炎症反应,促进伤口愈合过程中的血管生成,作为伤口敷料用于伤口愈合。

图1 制备3D聚己内酯/ε-聚赖氨酸改性壳聚糖纤维支架示意图
1. PCL/PCS纳米纤维支架的制备和物理化学性质首次用FT-IR分析了交联型PCS、纯CS和PLS的化学结构,如图2a所示,表明已成功地将PLS改造为PCS。应用于皮肤组织工程的纳米纤维支架应具有良好的亲水性,既能吸收溢出的组织液,又能为细胞的黏附和增殖提供水分环境。图2b显示了不同纳米纤维支架的动态接触角,PCL纳米纤维支架的表面接触角为118°,表现出明显的疏水性,与PCL相比,PCL/PCS纳米纤维支架具有良好的亲水性,有利于在组织工程中的应用。将四种纳米纤维支架的应力-应变测试结果如图2c所示。只有PCL/PCS-15和PCL纳米纤维支架具有良好的延伸性,接近人体皮肤的延伸率。当PCS从0增加到15wt%时,纳米纤维支架的断裂伸长率从30%提高到39.8%。然而,进一步增加PCS的用量,纳米纤维支架的断裂伸长率分别降低到31.7%(PCL/PCS-20)和20.1%(PCL/PCS-25) (图2d)。纳米纤维支架的弹性模数和拉伸强度显示出类似的趋势(图2e和f)。这些结果表明,过多的PCS会降低纳米纤维支架的强度,导致韧性降低,容易断裂。

图2 PCL/PCS纳米纤维支架的物理化学性质
图3a-e显示了PCL/PCS纤维支架的扫描电子显微镜照片和纤维直径。总的来说,所有样品都表现出典型的非织造纳米纤维结构,具有成层沉积的纳米纤维和较高的孔隙率。但是,加入PCS后会出现毛细纤维、珠状纤维和扁平带状纤维等不规则纤维,导致纤维直径分布不均匀,从而影响纳米纤维支架的力学性能。用Image J软件对纤维支架的平均直径进行测量和计数,发现在适当的PCS浓度下,纤维的直径分布符合正态分布,没有毛细和扁平的带状纤维(PCL/PCS-15),有利于纤维支架的制备和应用。

图3 PCL/PCS纳米纤维支架的扫描电镜图
2. 三维纳米纤维支架的物理化学评价通过静电纺丝制备的纳米纤维支架由随机堆积的纤维组成,形成了宏观上具有较低比表面积的2D致密纳米纤维膜结构(图4a1)。尽管在扫描电子显微镜下观察到纳米纤维支架彼此不粘连并且有大的空隙(图4a2),但纳米纤维支架由密集排列的纤维结构组成,这导致了严重的纳米纤维粘连。膨胀后,纳米纤维支架(3D PCL/PCS)的厚度从0.29 mm显著增加到2 mm(图4b1)。用扫描电子显微镜观察了三维PCL/PCS纳米纤维支架的表面和截面形貌(4b2和b3),纤维直径没有明显变化,但纳米纤维支架内部变得更加疏松。上述分析表明,在气体发泡过程中,会产生大量气泡,增加具有多层结构的支架层的孔隙率,导致纳米纤维支架厚度的增加。与未经Gel和HEP交联修饰的PCL/PCS纳米纤维支架相比,3D PCL/PCS@Gel/HEP纳米纤维支架的厚度、表面和横截面形态没有显著变化(图4c1-c3)。图4d显示了3D PCL/PCS@Gel/HEP纳米纤维支架的光学图像,可见3D PCL/PCS@Gel/HEP纳米纤维支架的表面疏松而粗糙地折叠(图4d2),横截面上有更明显的气孔(图4d3)。

图4 电纺PCL/PCS复合材料的形态结构
3. 纳米纤维支架的抗菌能力为了评价3D纳米纤维支架的抗菌活性,以大肠杆菌和金黄色葡萄球菌为模型菌,分别进行了细菌溶液浊度、抑菌圈试验、平板菌落计数法和细菌形态的扫描电子显微镜观察。图5a和b显示了在PCL/PCS和PCL/PCS@Gel/HEP纳米纤维支架组中,大肠杆菌和金黄色葡萄球菌菌落数显著减少。与对照组相比,PCL/PCS和PCL/PCS@Gel/HEP纳米纤维支架共培养24小时后,大肠杆菌和金黄色葡萄球菌的存活率仅为15%左右(图5c-d),而PCL纳米纤维支架组细菌存活率无明显变化。为了进一步研究3D PCL/PCS和PCL/PCS@Gel/HEP纳米纤维支架的抗菌性能,比较了抑菌圈大小。图5e和图5f显示了培养24小时后PCL/PCS和PCL/PCS@Gel/HEP纳米纤维支架的细菌抑制透明区远大于对照组。用扫描电子显微镜进一步观察了PCL/PCS和PCL/PCS@Gel/Hep共培养后的大肠杆菌和金黄色葡萄球菌的形态,如图5g-n所示,细菌的细胞膜破裂,导致细菌完全死亡。这些结果证实了含有PCS的纳米纤维支架破坏了细菌膜的完整性。
图5 3D PCL/PCS@Gel/HEP纳米纤维支架的体外抗菌活性
4. 体外血液相容性血液相容性在激活血细胞和启动伤口愈合过程中起着重要作用。如图6a和图b所示,PCL/PCS@Gel/HEP纳米纤维支架的溶血率为1.69%,低于PCL/PCS纳米纤维支架的4.85%,表明PCL/PCS@Gel/HEP纳米纤维支架无溶血作用。体外动态全血凝血时间实验图6c显示了纳米纤维支架的动态血液抗凝指数(BCI)和血液凝固光学照片。当纳米纤维支架与血液接触时间控制在5min时,PCL/PCS和PCL/PCS@Gel/Hep的BCI分别为88.33%和92.45%,高于对照组(64.91%),显示出最强的血栓抑制能力。

图6 PCL/PCS@Gel/HEP纳米纤维支架的血液相容性
5. 纳米纤维支架的生物相容性评价纳米纤维支架良好的生物相容性是其在组织工程中应用的重要前提。图7a和b显示了与空白对照组相比,不同纳米纤维支架组的细胞存活率,纳米纤维支架组与对照组相比无明显差异,说明纳米纤维支架材料具有较高的生物相容性。为了评估3D纳米纤维支架的细胞附着性,将细胞结合的纳米纤维支架培养1天和3天,用扫描电子显微镜对细胞形态进行了评价(图7g-j),第一天,三维PCL/PCS@Gel/HEP纳米纤维支架上附着着形态良好的细胞,细胞在纳米纤维支架上铺展良好,而2D PCL/PCS纳米纤维支架上几乎没有细胞。第3天,与2D支架相比,3D PCL/PCS@Gel/HEP纳米纤维支架上附着的细胞更多,表现出更好的细胞-基质相互作用。为了进一步评价3D纳米纤维支架对细胞增殖过程的影响,用流式细胞仪分析了细胞的凋亡情况,如图7c-f所示,纳米纤维支架不会对细胞产生额外的刺激进而诱导细胞凋亡。因此,制备的纳米纤维支架具有良好的生物相容性,满足作为创面愈合潜在组织支架材料的基本要求。

图7 PCL/PCS@Gel/HEP纳米纤维支架体外相容性实验
6. 创面在体内的愈合为了评估3D纳米纤维支架在伤口修复中的潜力,进行了SD大鼠全层皮肤损伤再生实验,以证实3D纳米纤维支架敷料促进创面愈合的能力。图8a显示了治疗6d后,纳米纤维支架组创面面积小于医用纱布组。另外,在三种纳米纤维支架组中,PCL/PCS@Gel/Hep+VEGF组创面面积最小。图8b显示PCL/PCS@Gel/Hep+VEGF组治疗10d后创面完全愈合,创面可见新生毛发生长。伤口面积和愈合率相对于伤口再生时间的计算进一步表明,PCL/PCS@Gel/Hep+VEGF组显示出良好的伤口闭合效率(图8c-d)。这些结果表明PCL/PCS@Gel/HEP复合纤维可作为潜在的组织工程支架用于组织再生。在纳米纤维支架中掺入血管内皮生长因子对创面愈合有协同促进作用。

图8 PCL/PCS@Gel/Hep+VEGF促进皮肤伤口愈合
7. 组织学和免疫组织化学评价H&E染色如图9所示,纳米纤维支架组的炎性细胞较纱布组少(黑色箭头),与医用纱条组相比,PCL/PCS@Gel/Hep+VEGF纳米纤维支架组创面宽度小于PCL/PCS@Gel/Hep组,可见更多的新生血管(红色箭头)和排列整齐的肌原纤维。第10天,PCL/PCS@Gel/Hep+VEGF纳米纤维支架组创面完全上皮化,可见更多的皮肤附属物(毛囊:绿色箭头,腺体:黄色箭头),再生组织结构接近正常皮肤结构。相比之下,使用其他纳米纤维支架治疗的伤口还没有完全愈合,只有几个毛囊和腺体。以上结果提示,3D PCL/PCS@Gel/HEP纳米纤维支架复合血管内皮生长因子可促进ECM改建和组织再生。

图9 PCL/PCS@Gel/Hep+VEGF纳米纤维支架的HE染色
伤口组织中胶原蛋白的含量也可以作为评估伤口再生效果的一种方法。图10a显示了马森染色的结果,PCL/PCS@Gel/Hep+VEGF中的胶原纤维结构完整,呈波状排列,密度较高,分布更均匀。在伤口愈合过程中,四组的胶原沉积持续增加(图10b)。免疫组织学染色如图10c和d所示,在第5天和第10天,PCL/PCS@Gel/HEP+血管内皮细胞生长因子纳米纤维支架组的肿瘤坏死因子-α的表达低于医用纱布组,表明这些纳米纤维支架具有更好的预防感染的能力。此外,如图10e和图f所示,在第5天和第10天,PCL/PCS@Gel/Hep和PCL/PCS@Gel/Hep+VEGF纳米纤维支架覆盖的创面CD-31阳性表达高于医用纱布组,促进了创面愈合过程中的血管生成。

图10 PCL/PCS@Gel/Hep+VEGF纳米纤维支架的马森和免疫组织学染色
基于上述结果,三维(3D)纳米纤维支架作为可替代创面敷料都具有明显的优势,与目前商业化的创面敷料相比,它在细胞黏附和生长方面可以接近ECM。体外研究表明,所制备的3D纳米纤维支架为细胞生长提供了富氧的湿润环境,有利于血管内皮生长因子的表达,并能很好地促进创面的血管生成。此外,3D纳米纤维支架在促进伤口愈合、抑制炎症、毛囊再生、血管生成和胶原沉积等全层皮肤缺损的修复方面优于2D微/纳米纤维膜。
文章来源://www.sciencedirect.com/science/article/pii/S174270612200558X